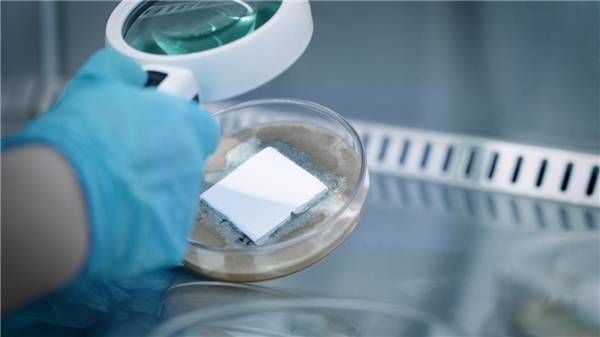

高端测评,见证嘉宝莉海藻泥4代墙面漆除醛净化黑科技
随着环保意识的崛起,当代年轻人在家居消费的选择上,更倾向于为绿色环保的产品买单。据报告显示,九成以上已婚家庭都将环保作为家居装修的首要考虑因素。而产品测评作为权威第三方机构对产品品质的专业考核认证,能帮助消费者了解真实的产品使用体验,辨别产品质量的高低,在消费者选购涂料产品时提供方向和指引。
今年6月份,全新上市的嘉宝莉海藻泥4代无添加全净全效墙面漆,正是针对家居环境中的甲醛污染问题,在预防和治理方面均卓有成效的一款优质产品。
近期,这款产品就被送到了华南—国家涂料产品质量检验检测中心进行检测。检测依据严格、公平、公正的国家标准,对海藻泥4代分别进行了遮盖力、防霉抗菌、甲醛VOC苯重金属含量、甲醛净化功能、耐污性能、耐擦洗性等六大维度的专业测试。

经受住严苛测评考验的海藻泥4代墙面漆作为嘉宝莉的王牌环保产品,实现了真正的全屋适用,全效守护家中敏感人群如儿童、孕妇、老人的呼吸健康,无惧甲醛侵扰,是众多家庭的家装首选。
0有害物+95%甲醛净化 海藻泥4代助力畅快呼吸
作为新型健康装饰涂料,嘉宝莉海藻泥4代墙面漆净化家居空气的能力始终突出。
一方面,海藻泥4代是低释放无添加的墙面漆,在产品配方设计和生产过程中未人为添加甲醛、苯、重金属及挥发性有机化合物,这就从根本上杜绝了涂料产品涂刷后有毒有害易挥发有机化合物在空气中的释放和残留。
在国家涂料产品质量检验检测中心的实验室中,测评工程师采取GB 18582-2020《建筑用墙面涂料中有害物质限量》为依据,对海藻泥4代墙面漆的VOC、甲醛、苯系物、铅、可溶性重金属、烷基酚聚氧乙烯醚的含量分别进行检测,检测结果显示,以上有害物质均未被检出。
另一方面,海藻泥4代墙面漆具有强效的吸附和分解甲醛的能力。海藻泥4代以深海海藻泥成分为原料,采用经国家专利认证的海藻泥空气净化型涂料制备技术,通过海藻泥表面独特的、具有物理吸附能力和离子交换能力的数以万计的微孔,迅速捕捉空气中的甲醛分子并分解成水分子,从而达到高效净化室内空气的效果。
在对海藻泥4代墙面漆的甲醛净化功能进行实验室测试时,测评工程师在两个实验舱中分别放入海藻泥4代样板与玻璃样板,并在两个舱中输入等量甲醛。在静置24小时后,分别抽取两个实验舱中的空气并融入试剂,再加入甲醛显色剂,并放入光谱仪中检测甲醛含量。检测结果显示,玻璃样板舱中甲醛浓度为84.35mg/m³,而海藻泥4代样板舱中甲醛浓度仅为3.46mg/m³,比对照组玻璃样板舱的甲醛含量低了95%,即甲醛净化率高达95%,远高于普通净醛涂料65%的净化率,证实能够有效帮助新家净化装修材料释放出的甲醛。
抗菌防霉易清洁 定义全屋适用高标准
除了出色的空气净化能力,嘉宝莉海藻泥4代墙面漆还兼顾了抗菌防霉、耐污耐擦洗等优异性能。
在抗菌防霉性能测试中,海藻泥4代墙面漆被放进装有细菌营养液的培养皿中,并送进恒温潮湿的密封箱中存放,20天后通过50倍放大镜观测,发现实验样板未被细菌和霉菌污染,证实了海藻泥4代墙面漆对金黄色葡萄球菌、大肠埃希氏菌的有效抗菌率为99%,达到行业标准中检测抗菌性能的最高标准Ⅰ级抗菌,同时对6种常见霉菌包括黑曲霉、土曲霉等的防霉性能达到0级标准,即检测结果未见霉菌生长,能有效抑制霉菌滋生,守护呼吸健康,也能最大程度降低墙面因发霉而脱落的风险。
而对于很多有孩家庭来说,除了满足健康环保的要求,海藻泥4代墙面漆耐污耐擦洗的特点,还能够帮助他们轻松抵御日常生活中常见的污渍,包括手印鞋印、水彩笔蜡笔等笔迹、果汁咖啡等液体污渍。相对于普通涂料,涂刷了海藻泥4代的墙面污渍更难渗透,即使墙面沾染上污渍,也只需使用湿抹布轻轻擦拭便能清洁干净。同时涂刷海藻泥4代的漆面坚韧程度极高,在实验中,即使承受机器3万次的反复擦洗,漆面也不破损,这就使得家居墙面更易清洁、更耐清洁。
权威环保认证加分 4代海藻泥系列墙面漆持续升级
早在2011年,国内领先的涂料品牌嘉宝莉便率先在行业中推出海藻泥涂料产品。海藻泥即海藻类沉积矿物质,其主要成分为蛋白质,质地轻柔,表面密布超细微孔,这种突出的分子筛结构决定了其具有极强的吸附功能和分子交换功能。以深海海藻泥成分为原料的嘉宝莉海藻泥系列墙面漆,能有效分解和吸附空气中的甲醛,从而达到净化室内空气,保持家居空间持久清新的目的。

11年间,嘉宝莉海藻泥系列墙面漆历经了四次迭代更新。通过汇聚行业专家,与国内知名高校建立产学研战略联盟,嘉宝莉一直致力于生产研发技术的升级和产品配方性能的完善,海藻泥系列墙面漆已得到包括美国UL GREENGUARD室内空气质量金级认证、法国室内环境检测A+标准、低释放标准室内空气A+检测认证等多项国内外权威环保认证。2022年,全新上市的嘉宝莉海藻泥4代无添加全净全效墙面漆更是通过了世界公认极其严苛的德国莱茵TÜV认证,标志着海藻泥系列产品卓越的环保实力再上台阶。
“让家美丽 让爱放心”是嘉宝莉一直坚守的品牌价值观,而海藻泥系列墙面漆强大的产品品质背后,彰显的是嘉宝莉对品牌价值的传承,以及对涂料行业绿色发展的坚守。相信在未来,越来越多的环保涂料产品将能为广大消费者的家居空间提供更为广泛的健康保障。
网址:高端测评,见证嘉宝莉海藻泥4代墙面漆除醛净化黑科技 https://c.jiaju82.com/news-view-id-825535.html

